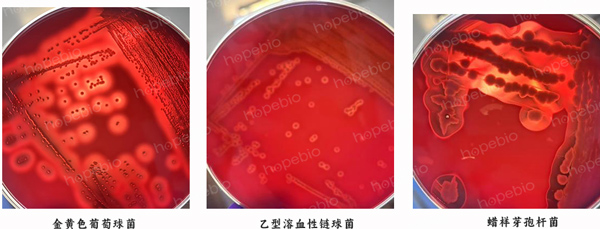

海博微信公众号
海博微信公众号
 海博天猫旗舰店
海博天猫旗舰店


 海博微信公众号
海博微信公众号
 海博天猫旗舰店
海博天猫旗舰店




一、原理及用途
脱纤维羊血中含有蛋白质和生长促进因子。常用于培养营养要求苛刻的微生物,如链球菌、支原体等。血液添加入含琼脂培养基中,不仅可促进微生物快速生长繁殖,也可以对微生物进行鉴别和观察溶血现象,不同的微生物有特定的溶解环。
TSBA平板主要用于微生物培养。
二、使用方法
接种以下质控菌株,放置30±1℃需氧培养24±2小时。
|
质控菌株 |
菌株编号 |
接种量(CFU) |
生长情况 |
结果 |
|
蜡样芽孢杆菌 |
ATCC11778 |
/ |
+++ |
完全溶血环 |
|
苏云金芽孢杆菌 |
ATCC10792 |
/ |
+++ |
完全溶血环 |
|
蕈状芽孢杆菌 |
ATCC10206 |
/ |
+++ |
呈现弱的溶血现象 |
|
巨大芽孢杆菌 |
ATCC14581 |
/ |
+++ |
不溶血 |
相关产品:
注:本文属海博生物原创,未经允许不得转载。
下一篇:没有了!



